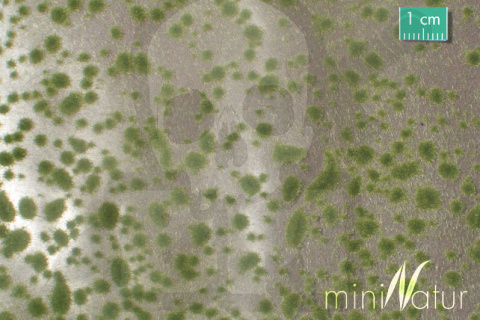
MiniNatur: Tuft - Wczesnojesienne kępki mchu (42x1 cm)

-
Koszyk jest pusty
-
x
Do bezpłatnej dostawy brakuje
-,--
Darmowa dostawa!
Suma
0,00 zł
Cena uwzględnia rabaty

0,00 zł
0
-
Koszyk jest pusty
-
x
Do bezpłatnej dostawy brakuje
-,--
Darmowa dostawa!
Suma
0,00 zł
Cena uwzględnia rabaty
-
MiniNatur: Tuft - Wczesnojesienne kępki mchu (42x1 cm)

Symbol:
SIL747-23
29.00
| Wysyłka w ciągu | 24 godziny |
| Cena przesyłki | 11.99 |
| Dostępność |
|
| Kod kreskowy | |
| EAN | 4048847747234 |
MiniNatur: Tuft - Wczesnojesienne kępki mchu (42x1 cm)
-
Jesień dla mchów to okres wzrostu - wśród ich zielonej i wilgotnej masy rosną grzyby, a one same powoli opanowują kolejne kawałki spróchniałych drzew oraz zmurszałych kamieni.
W zestawie MiniNatur: Tuft - Wczesnojesienne poduszki mchu znajdziesz folię nośną z kępkami materiału w kolorze wczesnojesiennego mchu, które można łączyć z trawą statyczną, filigranowymi drzewami oraz podsypką piankową.
Dane producenta
Silhouette Modellbau GmbH
Buschingstrasse 5
82216 Maisach - Gernlinden
Germany
+49081426526611
info@mininatur.de
Nie ma jeszcze komentarzy ani ocen dla tego produktu.
- Producenci









